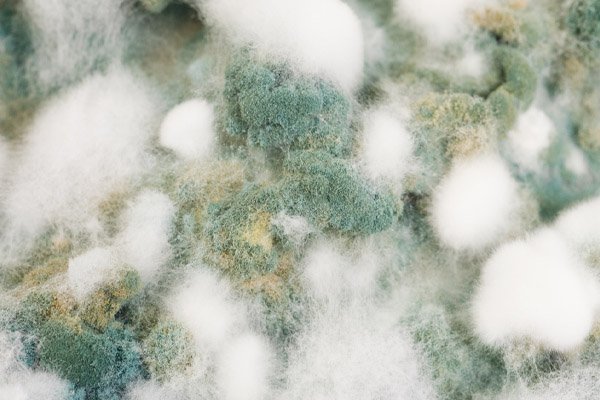
Плесень на прозрачном фоне

Текстуры плесени - это удивительное разнообразие форм и узоров, которые образуются при росте грибков на поверхности различных материалов. Они могут быть как мягкими и пушистыми, так и гладкими и лоснящимися, создавая уникальные композиции из различных оттенков зелени, синевы или черного цвета. Текстуры плесени привлекают внимание своей необычностью и красотой, заставляя нас видеть в них не просто грибковое поражение, а настоящее произведение искусства природы.

Плесень текстура

Плесень текстура

Зеленая плесень на стенах

Плесень текстура

Плесень текстура

Плесень текстура

Волосатик плесень

Плесень текстура

Плесень текстура
Плесень на прозрачном фоне

Плесень на бетонной стене

Плесень фактура

Плесень текстура

Плесень текстура

Грязь на стене

Плесень на стене текстура

Плесень текстура

Плесень текстура

Плесень текстура

Бетон с плесенью текстура

Плесень на стене текстура

Бетонная стена с плесенью текстура

Мох на бетонной стене

Плесень текстура

Стахиботрис грибок

Бетонная стена с плесенью текстура

Плесень на стене текстура

Плесень текстура









